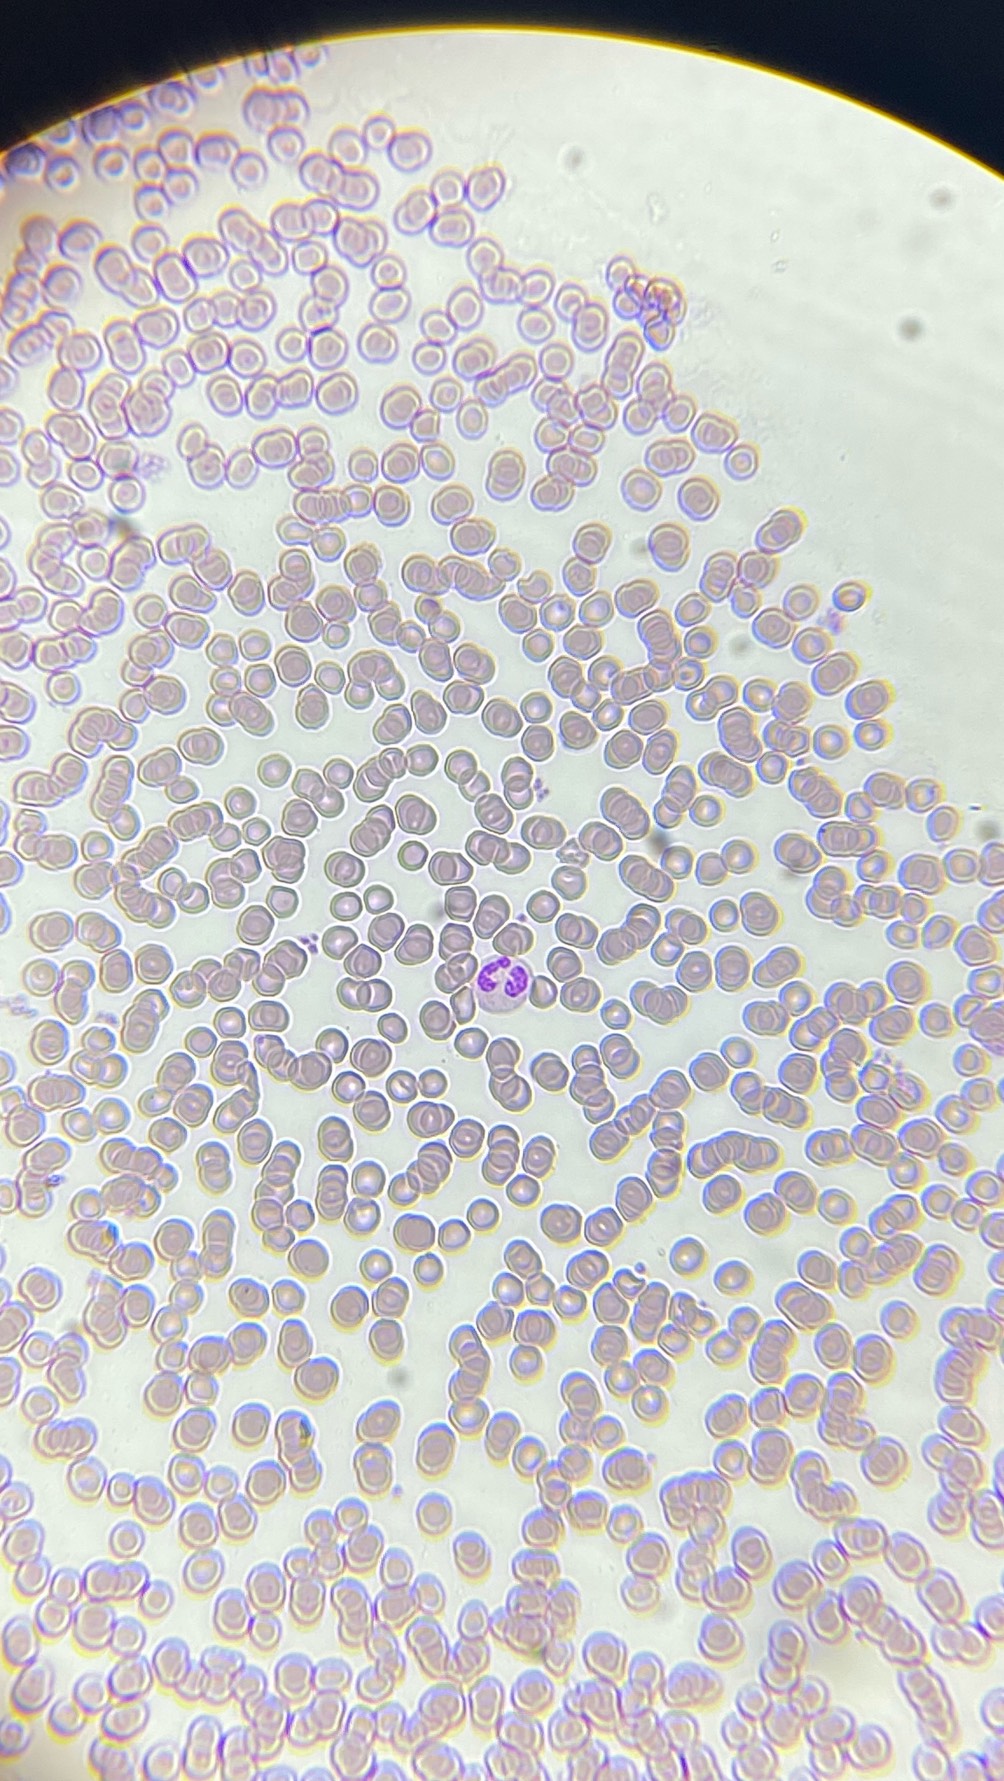
POST

์คํผ | DJ ๐ชผ๋์ ์ฑ๋
DJ ๐ชผ๋์ ๋ฐฉ์ก ์ ๋ณด์ ๋ค์ํ ์ค๋์ค ์ฝํ ์ธ ๋ฅผ ํ์ธํด ๋ณด์ธ์.
๐ชผ

๊ณต์ง์ฌํญ
์ง๋ ๋ฐฉ์ก ๋ค์ ๋ฃ๊ธฐ
์บ์คํธ
Top ํฌ
๐๐ข ๐บ.โบ
ow l
๐ฎ๐ด์๋
๋ฆฐ์
.
์ต์ ๋๊ฒ
๋ ์ฃผ
๊น ์ ์ธ
์คํ ๐ต๐๐ท๐ท ๐งฃ
ํฌ์คํธ
์ ์ ๊ท์ฌ์ด ์ ํ๊ตฌ์ ๋ฐฑํ๊ตฌ์์
์ ์ ๊ท์ฌ์ด ์ ํ๊ตฌ์ ๋ฐฑํ๊ตฌ์์